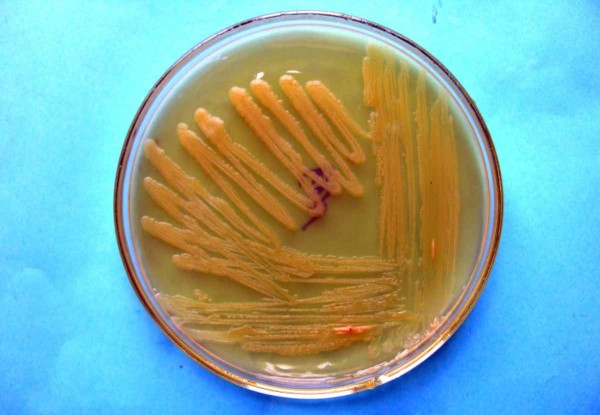
Bakteri&aacute;ln&iacute; kolonie Pectobacterium carotovorum subsp. carotovorum

Choroby bramboru 3: Bakteriální choroby bramboru (II.)
07. 10. 2020 Choroby Zobrazeno 1547x
Bakteriální černání stonku a měkká hniloba hlíz je běžně rozšířená choroba bramboru, která se vyskytuje především s vyšší relativní vlhkostí. Původci choroby jsou druhy rodu Pectobacterium, Dickeya a Pseudomonas.
Bakteriální černání stonku a měkká hniloba hlíz
Bakteriální černání stonku a měkká hniloba hlíz je běžně rozšířená choroba bramboru, která se vyskytuje především s vyšší relativní vlhkostí. Původci choroby jsou druhy rodu Pectobacterium, Dickeya a Pseudomonas. Společnou vlastností těchto bakterií je schopnost produkovat enzymy, které rozkládají pektiny tvořící pojivo mezi rostlinnými buňkami, dochází tak k měknutí pletiv. Průvodním znakem je nepříjemný zápach. Působením těchto patogenů dochází ke špatné vzcházivosti, později mezerovitosti porostu, a tím snížení výnosu. Bakterie také často způsobují sekundární infekce, kdy dokončují rozklad hlíz primárně napadených jinými patogeny, např. Phytophthora infestans nebo Fusarium spp.
Pectobacterium atrosepticum, starším názvem Erwinia carotovora subsp. atroseptica napadá pouze brambor, zatímco patogeny Pectobacterium carotovorum subsp. carotovorum (syn. E. carotovora subsp. carotovora) a Dickeya chrysanthemi (syn. Erwinia chrysanthemi) jsou polyfágní druhy, mají široký okruh hostitelů.
Typickým příznakem je černání báze stonku (tzv. černá noha), zpočátku pod povrchem půdy, později se šíří směrem nahoru na nadzemní část. Příznaky černání stonku se liší podle toho, ve které vývojové fázi byla rostlina napadena. Při deštivém počasí mohou bakterie napadat i vegetační vrcholy nebo způsobovat měkké černé nekrotické léze na kterékoliv části stonku. Na příčném řezu stonkem můžeme pozorovat zhnědlé cévní svazky a rozpad pletiv. Postiženy mohou být jednotlivé stonky nebo celý trs. Jednotlivé listy se stáčí směrem vzhůru, rostlina vadne, žloutne a postupně odumírá.
Na hlízách vyvolávají bakterie měkkou hnilobu, která je charakteristická nepříjemným zápachem. Zpočátku se choroba projevuje zhnědnutím cévních svazků (připomínající příznaky bakteriální kroužkovitosti bramboru), v další fázi dochází k rozkladu pletiv v místě připojení stolonu a následně rozšíření rozkladu do dřeňové části hlízy.
Bakterie jsou gramnegativní, pektinolytické, fakultativně anaerobní, bičíkaté tyčinky s různou optimální teplotou růstu: 21–26 °C (P. atrosepticum), 26–30 °C (P. carotovorum subsp. carotovorum) a 37 °C (Dickeya chrysanthemi).
Patogen přežívá na hlízách (v lenticelách) nebo uvnitř hlíz (v cévních svazcích) a v posklizňových zbytcích (nesklizených hlízách). K infekci hlíz dochází přes lenticely nebo také mechanickým poškozením při sklizni a posklizňové úpravě. V průběhu skladování se může patogen šířit kontaktem. Na velké vzdálenosti se šíří kontaminovanou a infikovanou sadbou.
Na chorobě se mohou podílet i bakterie Pseudomonas viridiflava a Pseudomonas marginalis. Jsou to gramnegativní, bičíkaté, tyčinkovité bakterie, jsou také pektinolytické, ale na rozdíl od bakterií rodu Pectobacterium a Dickeya jsou aerobní, potřebují k životu kyslík. Optimální teplota růstu je 25–30 °C.
Základním preventivním opatřením je zdravá, nekontaminovaná sadba. Účelné je vysazovat narašenou nebo naklíčenou sadbu. V množitelských porostech pak odstraňovat napadené trsy. Po sklizni je důležitým opatřením naskladňování suchých hlíz a v průběhu skladování větrat, aby se zabránilo srážení vody na hlízách, a tím i vzniku infekce.

Příznaky bakteriálního černání stonku

Měkká hniloba v pupkové části hlízy bramboru na podélném řezu

Měkká hniloba v okolí lenticel hlízy bramboru

Test na odlišení pektinolytických bakterií
Bakteriální kolonie Pectobacterium carotovorum subsp. carotovorum

Bakteriální kolonie Pseudomonas marginalis

Kolonie pektinolytické bakterie Dickeya chrysanthemi na živném médiu
Další články v kategorii Choroby












RSS
RSS